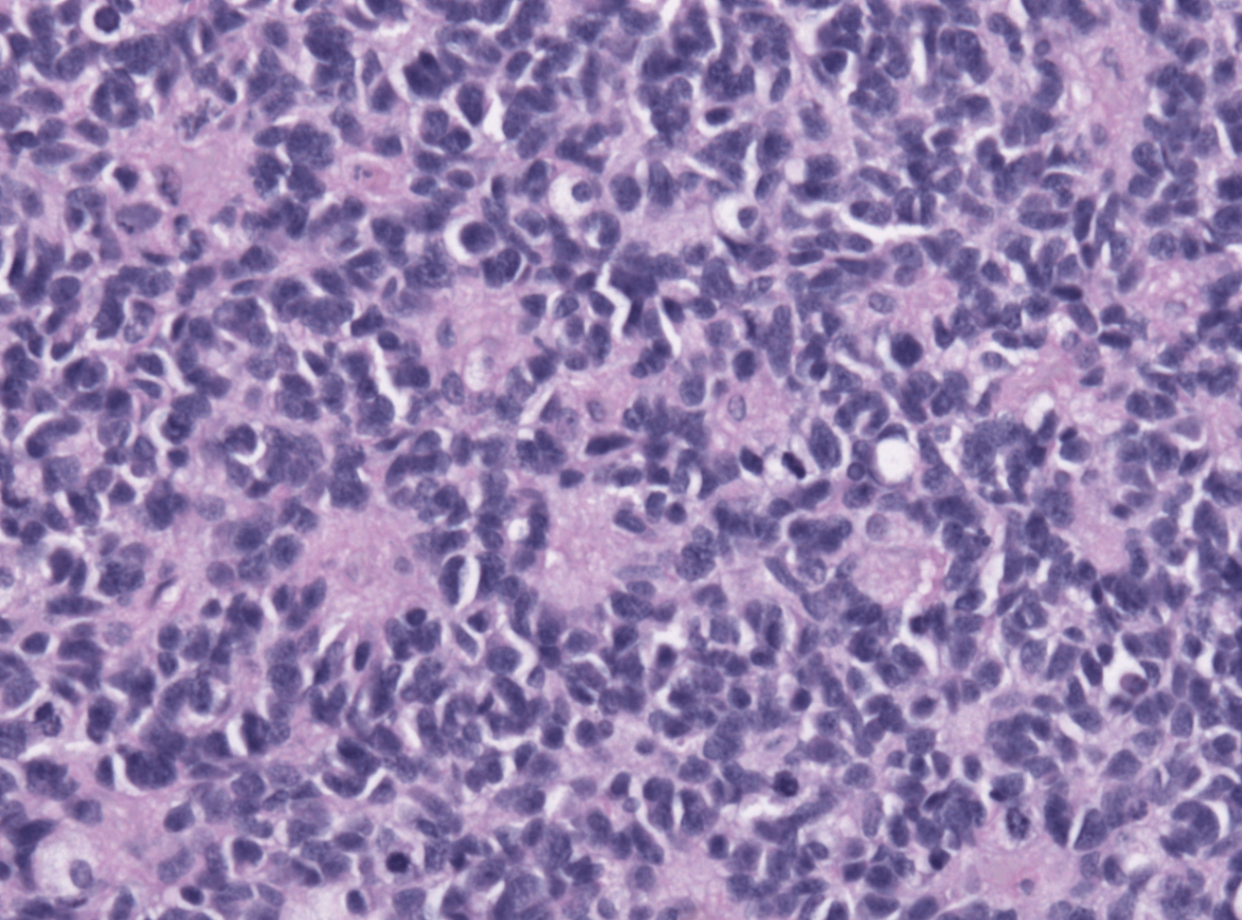

[기종평20]
0
여기에 표시한 문제들은 마이노트에서 모아볼 수 있어요!
11세 남자가 3주 전부터 왼쪽 다리가 아프다며 병원에 왔다. 영상의학검사에서 좌측 대퇴골 몸통에 골 피질부터 연부조직까지를 침범하는 덩이가 있다. 골 조직검사 사진이다. 염색체 검사에서 t(11;22)가 있다. 진단은?
정답률 64%
누적 풀이 횟수 100+
평균 풀이 시간18초
/
나의 풀이 시간0초
해설
[유잉육종 및 원시신경외엽종양, Ewing Sarcoma Family Tumors]
• Ewing Sarcoma Family Tumors는 t(11;22)(q24;q12) translocation에 의한 EWS-FLI1 fusion gene이 유발하는 악성 골종양이다.
• 기존의 Ewing sarcoma와 원시신경외엽종양 (primitive neuroectodermal tumor)가 같은 발병 기전을 공유한다는 사실이 밝혀지면서 Ewing Sarcoma Family Tumors로 합쳐지게 되었다.
• 아직 기원이 되는 세포에 대해 정확히 밝혀진 바가 없으며, 주로 어린이와 청소년의 긴 뼈 (ex. 대퇴골, 골반)와 평평한 뼈를 침범한다. 조직학적 소견으로는 핵이 둥글고 세포질이 거의 없는 종양세포가 특정한 패턴 없이 빠르게 증식하며 주변 조직을 침범하는 것이 관찰된다.
오답 풀이
• 골육종(osteosarcoma)는 뼈의 원발성 악성 종양으로, 전체 뼈암의 약 20%를 차지한다. 사춘기 성장 급증 시기에 발생률이 가장 높으며, 장골의 골간단(metaphysis) 부위에 호발한다. 파괴적이며 혼합성 용해성(lucent)과 골형성(blastic) 병변이 특징적이다. 종양이 골막을 들어올리며 Codman 삼각형(Codman triangle)이라는 특징적 방사선 소견을 보인다 .악성 세포는 무기질화되지 않은 골 또는 무기질화된 뼈를 형성하며 이를 통해 진단이 확정된다. 형성된 구조는 fine and lacelike 하거나 broad sheet 또는 trabeculae 형태를 가질 수 있다

• 연골육종(chondrosarcoma)는 연골(cartilage)을 생성하는 악성 종양이다. 골육종 다음으로 흔한 악성 기질(matrix)을 생성하는 골종양이다. 주로 중년 및 고령층에서 발생하며, 서서히 진행하는 통증과 국소 부종이 주요 증상이다. 뼈 내부와 인접 연부 조직을 침범하여 점진적으로 악화된다.
• 수질모세포종(medulloblastoma)은 소아에서 가장 흔한 악성 소뇌 종양으로, 신경외배엽(neuroectodermal) 기원의 원시 신경세포로 구성되어 있다. 주로 소뇌의 중심부(vermian region)에 발생한다. 미분화된 소형 청색세포(small blue cells)가 밀집하여 형성된 병변으로, 세포 밀도가 높고 핵이 과염색성을 보인다. 종양 내 Homer-Wright rosettes를 형성할 수 있으며, 신경세포분화의 특징을 나타낸다.
• 신경모세포종 (neuroblastoma)은 주로 소아에서 발병하는 신경계의 악성 종양으로, 가장 흔하게는 부신에 존재하는 primordial neural crest cell에서 기원한다. 조직학적으로는 작고 짙은 핵의 세포들로 이루어져 있으며, Homer-Wright pseudorosette이 흔히 관찰된다.

관련 이론
• 골종양
Reference
• Robbins and Cotran, Pathologic Basis of Disease, 10e
